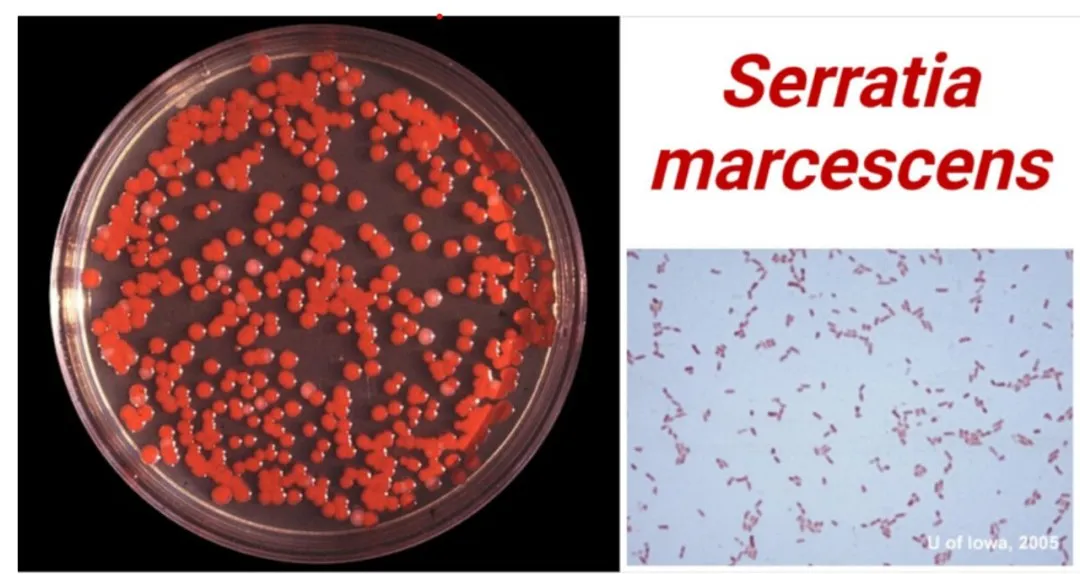

有约君说
你家有没有这一个奇怪现象?
厕所的一些卫生死角,比如马桶、洗手盆、瓷砖、水槽等,时不时会出现淡红色或粉色的污渍。
↓↓↓

图片来自网友
还有不少网友反映,
受到波及的不止卫浴大件,
还有牙刷、毛巾、浴帘……

图片来自网友
这种红色污渍到底是什么来头?
是霉菌?铁锈?还是水垢?
它对我们的身体健康有害吗?
怎么才能将它“赶尽”?
浴室里的神秘红渍:
粘质沙雷氏菌
这种不难清除、但总会卷土重来的淡红色污渍,其实是一种细菌——粘质沙雷氏菌。
据“科普中国”介绍,粘质沙雷氏菌(Serratia marcescens)又名灵杆菌,是自然界中最小的细菌。
粘质沙雷氏菌广泛存在于潮湿的环境中,比如浴室、洗涤槽、厨房排水口以及其他自然环境;而在人体内部,粘质沙雷氏菌常见于上呼吸道、泌尿道以及消化道。
因为粘质沙雷氏菌能产生一种名叫灵菌红素的脂溶性红色色素,所以菌落呈现漂亮的淡红色或粉色,因此还有“细菌界的颜值担当”之称。
好看归好看,它对人体到底有没有伤害?
(资料图/阜外华中药学部)
粘质沙雷氏菌是一种环境条件致病菌(机会病原体),通常不会感染健康人群,一般除了污染居住环境,让浴室和厨房变得脏脏的之外,危害不算很大。
但对于免疫力低下的人群,可能有导致尿路感染、伤口感染甚至眼部感染等风险,容易给呼吸道黏膜、胃肠道黏膜、泌尿系统黏膜带来一定损伤。
值得注意的是,由于大多数粘质沙雷菌对几种抗生素具有耐药性,加上它能够在附着的物体表面上形成生物膜,这使得常规清洁方法难以彻底清除它们,从而增加了感染的风险。目前,第三代头孢菌素及喹诺酮类抗菌药物对沙雷菌仍有强大抗菌活性。
知多点:
浴室里常见的红色污垢,除了粘质沙雷氏菌,还有说法认为其可能属于红酵母菌。
比如属于红酵母属的胶红酵母,它广泛分布于空气、土壤、湖泊和海水中,常寄生于植物、人类和其他哺乳动物。由于它对塑料有很强的亲和力,可在塑料表面形成生物膜,可从浴帘、浴缸和牙刷分离到,也是一种机会性病原体。
对付厕所里的红酵母菌也不难,一般用浴室专用清洁剂或用50℃以上热水浇一会,就可以清除。
为什么粘质沙雷氏菌
总会“卷土重来”?
经常做浴室清洁的朋友都会发现,这种淡红色污渍通常并不难清除,抹布搭配浴室专用清洁剂就能较容易擦去。
但是往往过不了多久,它就会卷土重来,尤其是在潮湿的环境下,有时它甚至能一夜之间“疯长”,这又是为什么?
关于这个问题,科普专家认为有几种可能性:
1.家里安装了前置净水设备
原则上,粘质沙雷氏菌很难在含氯的自来水中生存。但有一种情况除外——家里安了前置净水设备,除掉了自来水中大部分的氯,这就给了粘质沙雷氏菌繁殖空间。
应对:当发现净水器出水口有淡红色污渍时,记得清洁净水器内或替换滤芯。
2.未及时清理储水设备
家中一些储水设备,如果水放置时间过长,自来水中残留的氯会消散,就可能滋生粘质沙雷氏菌,过度繁殖还会出现果冻状的菌落。
以下设备是“高风险区”:
马桶水箱
智能马桶喷头
有储水功能的莲蓬头
加湿器
挂烫机
扫地机器人的水槽
家用饮水机的内部管道
宠物喂水器等
应对:储水设备内没用完的水应及时清理,定期做好清洁。
3.小区有高层储水系统
如果排查完家中卫生情况、设备情况,仍有红色污渍出现,就要考虑可能是高层住宅的储水系统方面的问题了。
出于高层用水和水压等问题考虑,一些高层住宅会提前将自来水抽到位于楼顶的水箱里储存,如果水箱卫生情况不好,再加上水中的氯被放置掉,就有可能会产生粘质沙雷氏菌,进入每家每户。
应对:如果小区太长时间未进行水箱清洁,应提醒物业公司。
浴室里黑色、黄色污渍又是什么?
我们在日常生活中,还经常在浴室、厨房等常用水的区域,发现一些黑色的、黄色的污垢,它们对健康有影响吗?
黑色污渍——霉菌
卫生间里的黑色霉菌可不是“善茬”,它不但长得碍眼,而且会扎根到附着物内部导致难以清除(比如马桶、台盆边缘),还会危害人体健康。
比如近年频频上热搜的曲霉菌,人体长期接触或吸入,可能诱发肺炎、过敏,它还是国际公认的致癌物质,已被世卫组织列入I类致癌物。
对付霉菌必须“赶尽杀绝”,可以使用专业的溶菌酶、除霉剂,也可使用经稀释的消毒水,或3%的过氧化氢,或水与白醋按照1:1调配进行清洁。
黄色或白色污渍——水垢
水垢主要有两类。一类是水中的铁离子结晶后形成的水垢,多呈橙色或黄色。这种水垢一般产生在台盆等有少量水不断流出的地方。
另一类水垢是水中钙离子或镁离子的结晶,呈白色。对尚残余水分的地方通过某种方式进行加热就会产生这种水垢,比如多见淋浴间的玻璃上。
对付水垢,第一类(铁)可以用草酸,第二类(钙)可以用醋或者柠檬酸,而盐酸对任何水垢都有效果,选浓度较低家用盐酸即可。
如何清洁浴室不留死角?
攻略收好!
如何才能去除细菌、霉菌及各种污垢?除了避免卫生间积水、潮湿,保持室内通风干燥,还要养成良好卫生习惯,定期做好清洁尤为重要。
临近年底,是时候给卫生间来一次大扫除啦!攻略收好——



(图/健康中国)
综合自科普中国、科学世界、健康中国、京港感染论坛、阜外华中药学部
图/健康中国、网络资料
广州日报新花城编辑:李津